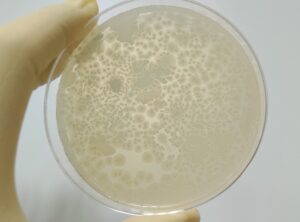

Microbial mix could help improve coccidiosis management in broilers
Using a dietary supplement containing a blend of Bacillus bacterial strains appears to positively affect the intestinal health and immunity of broiler chicks after a coccidia challenge, according to a Frontiers in Microbiology report.










